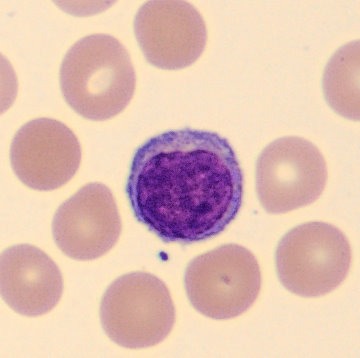
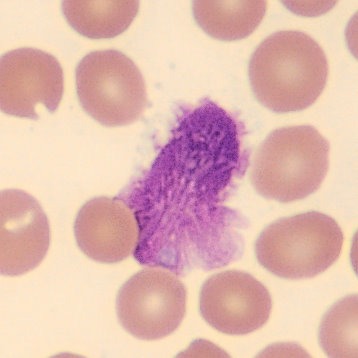

Leucemia Linfocítica Crônica
A leucemia linfocítica crônica (LLC) é uma neoplasia caracterizada pelo acúmulo de linfócitos B maduros no sangue periférico, medula óssea e órgãos linfóides. Apesar de ser a leucemia mais comum em adultos nos países ocidentais, seu comportamento clínico é extremamente variável, o que exige uma análise laboratorial criteriosa.
Nesse cenário, o laboratório não tem apenas papel diagnóstico, mas também prognóstico e de acompanhamento. A interpretação correta dos achados hematológicos é determinante para direcionar condutas e evitar erros na avaliação da doença.
(Linfócito maduro)
Achados hematológicos da Leucemia Linfocítica Crônica na prática laboratorial
O principal achado inicial da LLC é a linfocitose persistente no hemograma, frequentemente identificada de forma incidental. Esses linfócitos são, em geral, pequenos e maduros, com cromatina condensada e sem nucléolo evidente, podendo estar associados às chamadas manchas de Gumprecht.
(Mancha de Gumprecht)
Além disso, alterações como anemia e trombocitopenia podem estar presentes, especialmente em estágios mais avançados, refletindo comprometimento medular. A correlação entre essas alterações e o estágio clínico é essencial, já que níveis reduzidos de hemoglobina e plaquetas indicam pior prognóstico.

Imunofenotipagem e confirmação diagnóstica na Leucemia Linfocítica Crônica
A citometria de fluxo é indispensável para o diagnóstico da LLC, permitindo a identificação do perfil imunofenotípico característico dos linfócitos B neoplásicos. A coexpressão de marcadores como CD5 em células B, associada a outros antígenos específicos, confirma a natureza da doença.
Além do diagnóstico, a imunofenotipagem também fornece informações prognósticas relevantes. Marcadores como CD38 e ZAP-70, quando expressos em níveis elevados, estão associados a formas mais agressivas da doença, reforçando a importância da análise além do básico.
Marcadores laboratoriais e prognóstico na Leucemia Linfocítica Crônica
Diversos parâmetros laboratoriais têm sido estudados como preditores de evolução na LLC. O tempo de duplicação linfocitária, por exemplo, pode indicar maior agressividade quando reduzido, embora tenha perdido espaço para marcadores mais específicos.
Entre os marcadores mais relevantes, destacam-se alterações citogenéticas como deleções cromossômicas e o estado mutacional dos genes IgVH. Pacientes com perfil não mutado tendem a apresentar doença mais agressiva, enquanto os mutados costumam evoluir de forma mais indolente.
Conclusão
A LLC exemplifica como a hematologia laboratorial vai muito além da identificação de alterações no hemograma. O diagnóstico e o prognóstico dependem da integração entre morfologia, imunofenotipagem e marcadores biológicos.
Portanto, mais do que reconhecer padrões, o profissional precisa desenvolver raciocínio crítico para interpretar os achados de forma contextualizada. É essa capacidade que transforma dados laboratoriais em decisões clínicas seguras.

Referências
YAMAMOTO, Mihoko; FIGUEIREDO, Vera L. P. Epidemiologia da leucemia linfocítica crônica e leucemia linfocítica crônica familiar. Revista Brasileira de Hematologia e Hemoterapia, v. 27, n. 4, p. 229-232, 2005.
VASCONCELOS, Yuri. Marcadores de prognóstico na leucemia linfocítica crônica. Revista Brasileira de Hematologia e Hemoterapia, v. 27, n. 4, p. 253-256, 2005.
GONÇALVES, Romélia P.; MAIA, Daniel P.; CUSTÓDIO, Richeyla K. A.; MACHADO, Rosângela P. G.; DUARTE, Fernando B.; SILVA, Lilianne B. Avaliação do perfil hematológico de pacientes com leucemia linfocítica crônica (LLC-B) em um hemocentro estadual. Revista Brasileira de Hematologia e Hemoterapia, v. 31, n. 4, p. 228-234, 2009.


